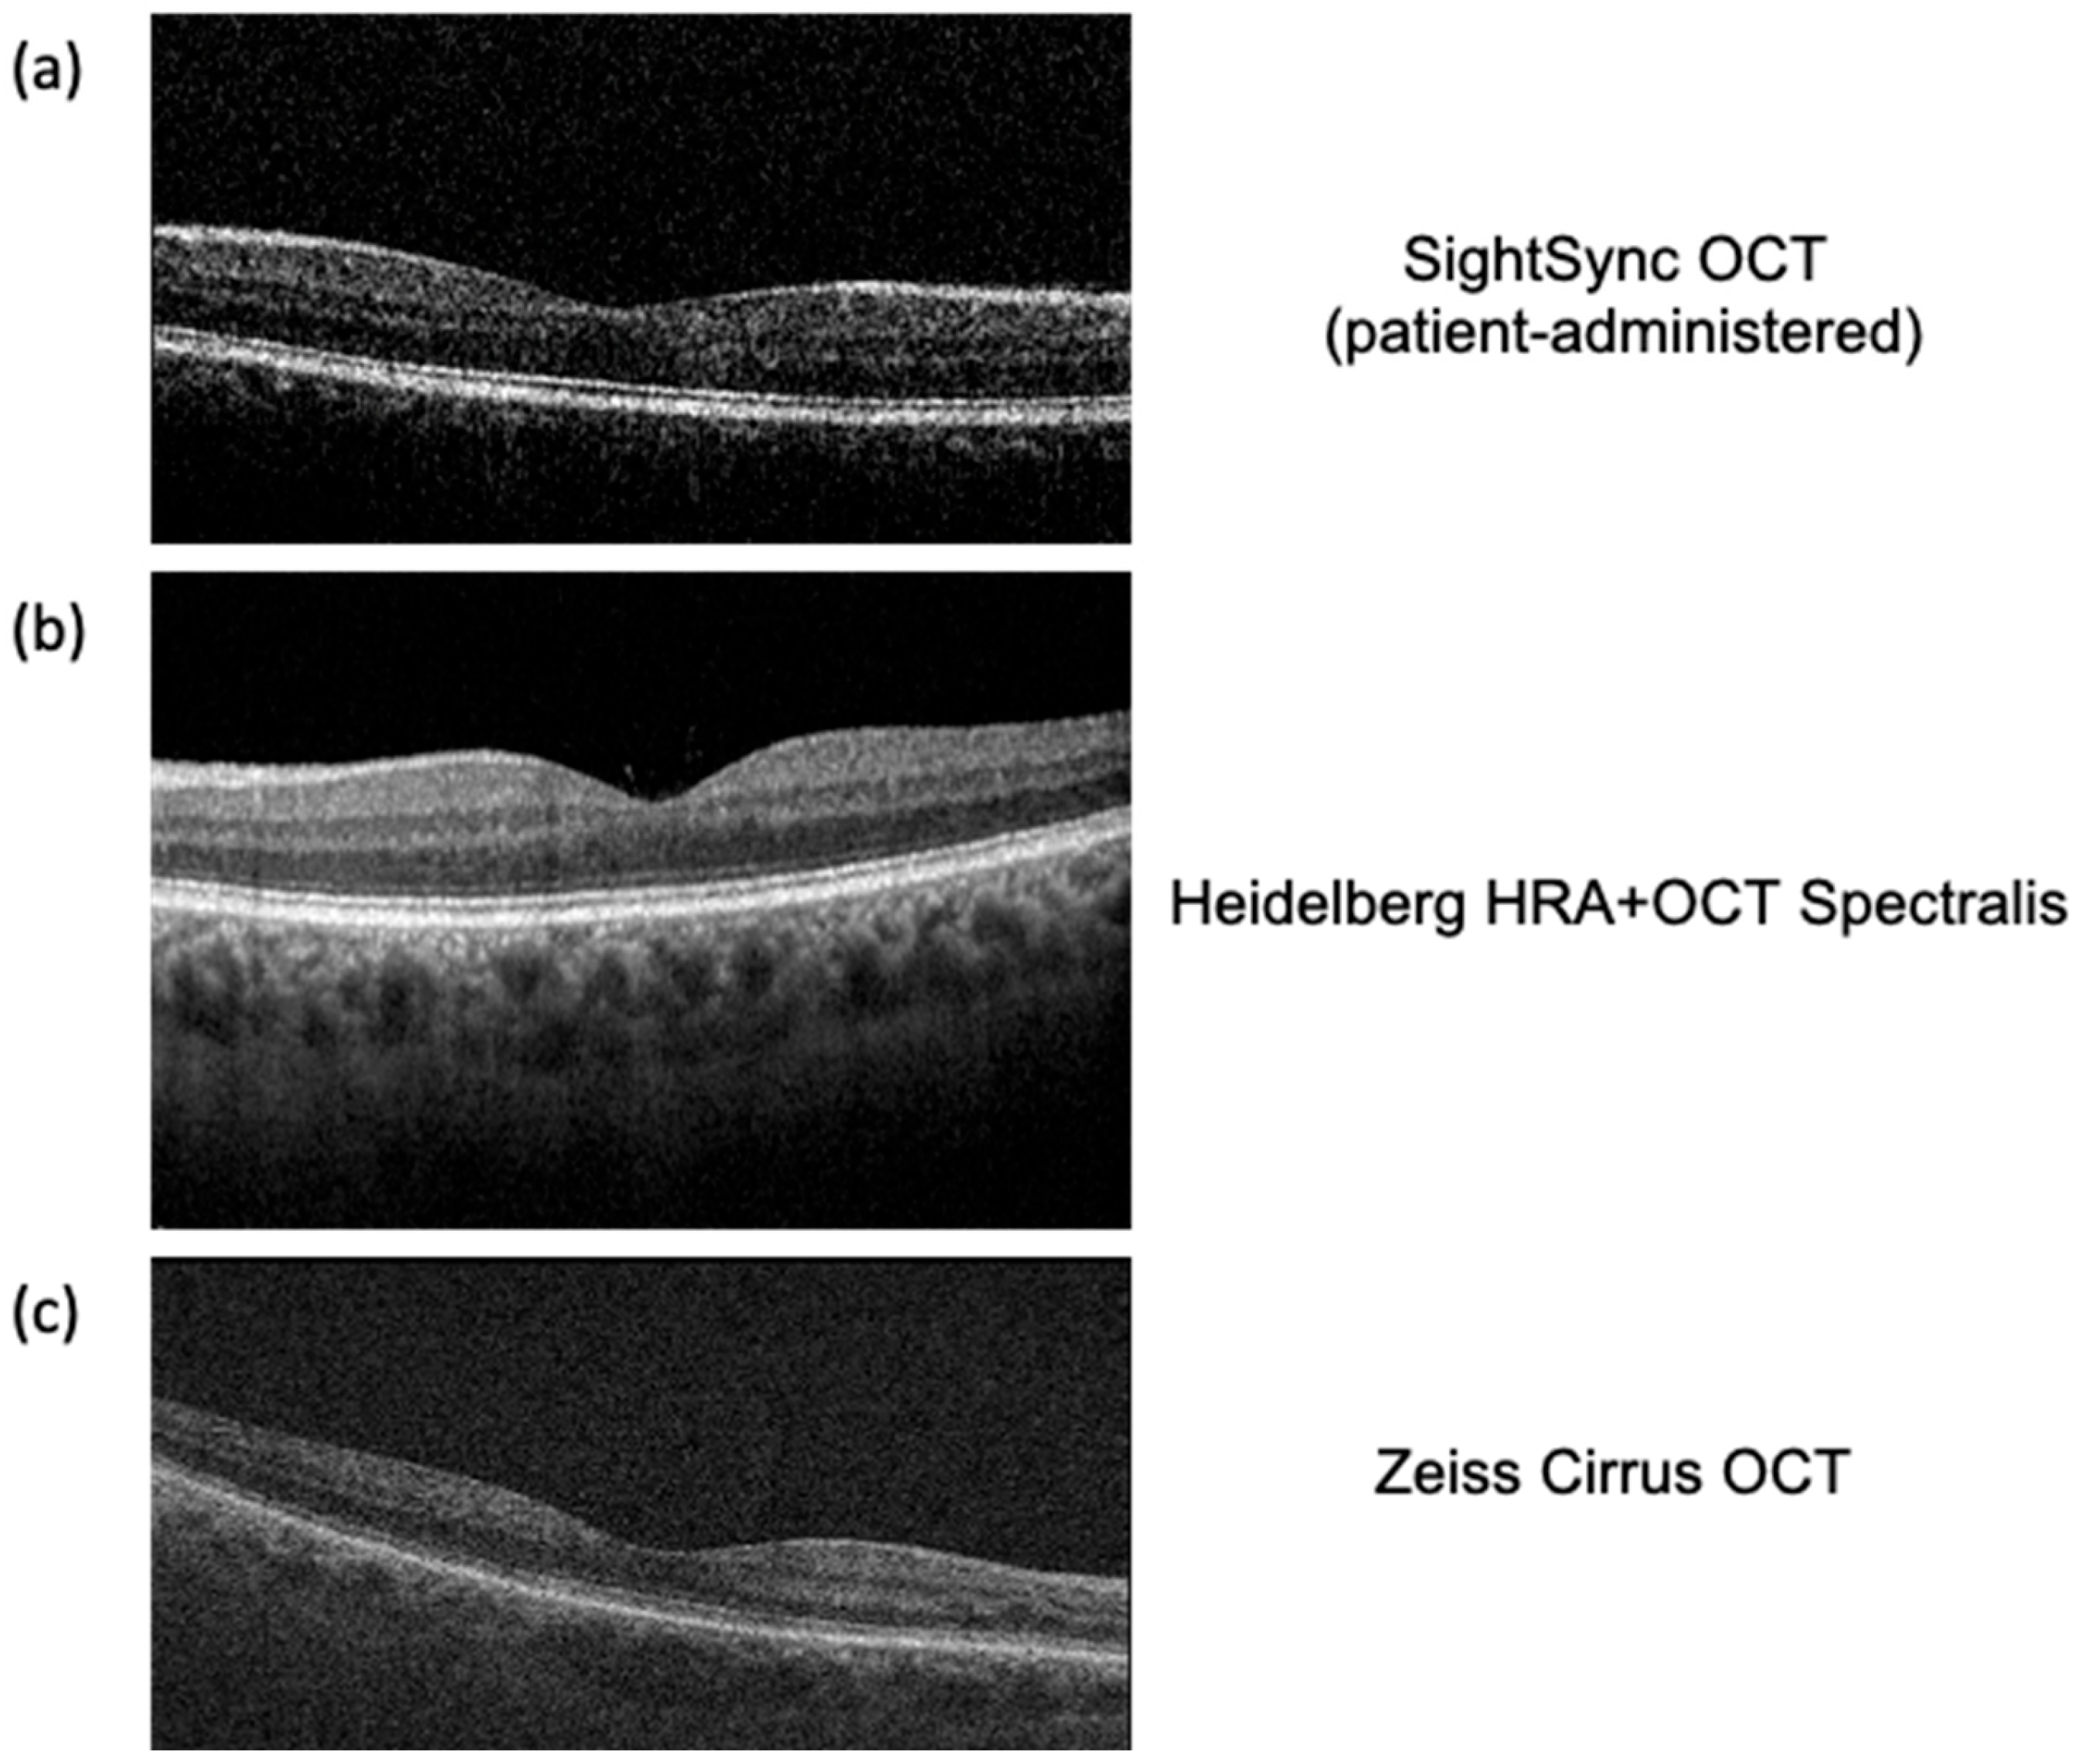
Bioengineering 12 00441 g004 Bioengineering 12 00441 g004

Recent Optical Coherence Tomography (OCT) Innovations for Increased Accessibility and Remote Surveillance
Abstract
1. Introduction
2. Principles of OCT in Retinal Disease
| Feature | TD-OCT (Time-Domain OCT) | SD-OCT (Spectral-Domain OCT) | SS-OCT (Swept-Source OCT) |
|---|---|---|---|
| Light Source | Broadband light source, split to sample and reference arms and interference detected by moving reference mirror | Broadband light with interference detected by spectrometer | Tunable laser swept across different wavelengths with interference detected by a single photodetector |
| Axial Resolution | 8–10 µm | 5–7 µm | 11 µm |
| Scan Rate | 400 A-scans/s | 20,000–52,000 A-scans/s | 100,000–236,000 A-scans/s |
| Clinical Utility | Basic imaging of retina | Standard for diagnosing and monitoring most retinal diseases | Choroid, anterior segment, and deep tissue imaging |
| Benefits | Lower cost | High-resolution, fast, widely available | Best depth penetration (able to obtain choroidal images), highly detailed |
| Limitations | Slow, low resolution, motion artifacts | Limited depth penetration | Costly, limited availability |
3. Biomedical Engineering Innovations in OCT Technology
| Feature | Envisu C2300 OCT (Leica Microsystems) | iVue (Optovue) | Spectralis Flex Module (Heidelberg Engineering) | Notal Vision’s Scanly Home OCT |
|---|---|---|---|---|
| Size | Dimensions: NPD, handheld | Dimensions: 19.1 × 34.4 in (26.3–34.3 height), tabletop | Dimensions: NPD, tabletop (with flexible boom arm) | Dimensions: NPD, tabletop |
| Weight | 3.31 lbs (1.5 kg) | 79 lbs (35.83 kg) | NPD | NPD |
| Scan Rate | 32,000 A-scans/s | 80,000 A-scans/s | 85,000 A-scans/s | 10,000 A-scans/s |
| Axial Resolution | 4 µm | 5 µm | 6 µm | 19 µm |
| No Technician Required | No | No | No | Yes |
| Deployment | Clinic | Clinic | Clinic | Home |
| Clinical Significance | Diagnosis, disease monitoring | Diagnosis, disease monitoring | Diagnosis, disease monitoring | Screening |
| Cost | NPD | $10k for base model | NPD | NPD |
4. SightSync: A Community-Model OCT
5. Technicianless, Easy-to-Use OCT
6. Secure Data Transfer in a Public Setting
7. Image Quality Validation and Analysis
| Model (Year) | Pathologies Detected | Performance (Metrics) | Source (Reference) |
|---|---|---|---|
| Kermany et al. CNN (2018) | Choroidal neovascularization (wet AMD), diabetic macular edema (DME), drusen (dry AMD), and normal retina. | Accuracy ≈ 96.6%, Sensitivity 97.8%, Specificity 97.4%, AUC 0.999 in classifying OCT scans (AMD/DME vs. others) | Cell (2018)—UCSD/Mendeley OCT dataset [78] |
| DeepMind OCT AI (2018) | Over 50 retinal conditions (e.g., age-related macular degeneration, diabetic eye disease, retinal detachment, etc.) | AUC > 0.99 for most conditions (≥0.96 for all); ~94% accuracy in recommending correct referral urgency | Nature Medicine (2018)—Moorfields Eye Hosp. & DeepMind [79] |
| Moorfields/DeepMind AMD Prognosis (2020) | Risk of conversion to exudative (“wet”) AMD in patients with early/intermediate AMD | Performed as well as or better than expert clinicians in predicting 6-month progression to wet AMD (higher predictive accuracy) | Nature Medicine (2020)—Moorfields Eye Hosp. & DeepMind [80] |
| f-AnoGAN (2019) | Unsupervised anomaly detection—tested on OCT identifying retinal fluid anomalies (e.g., fluid in AMD or DME). | AUC ~0.85 and Sensitivity ~88% for detecting anomalous OCT B-scans with fluid (outperformed other methods in experiments) | Med. Image Anal. (2019)—Schlegl et al. (Medical Univ. Vienna) [81] |
| 3D ResNet (CUHK) Glaucoma AI (2019) | Glaucomatous optic neuropathy (detection of glaucoma from optic-disc OCT volumes) | Primary validation AUC 0.969, Sensitivity 89%, Specificity 96%, Accuracy 91% (similar performance on external test sets). | Lancet Digital Health (2019)—Li et al. (CUHK/Stanford) [82] |
| RETFound Foundation Model (2023) | Multiple retinal diseases (foundation model pretrained on OCTs, fine-tuned for AMD, diabetic retinopathy, etc.) | Achieved state-of-the-art on various eye disease detection tasks, outperforming conventional models with fewer labels | Nature (2023)—Zhou et al. (Moorfields/UCL) [83] |
| AMD Stage Classifier—PINNACLE (2023) | Age-related macular degeneration stages: normal, intermediate (iAMD), geographic atrophy (GA), neovascular AMD (nAMD) | ROC–AUC ≈ 0.94 (averaged over AMD stage classifications) on real-world OCT volumes; balanced accuracy ~90% on internal test | Sci. Reports (2023)—Leingang et al. (Med. Univ. Vienna) [84] |
| ZEISS CIRRUS PathFinder (2024) | Macular OCT abnormalities (flags B-scans with subretinal fluid, intraretinal fluid, RPE atrophy or elevation, retinal layer disruptions, etc.) | ~88% sensitivity and 93% specificity for automatically detecting OCT scans with pathological findings (internal validation). | ZEISS CIRRUS PathFinder (2024)—FDA-pending product [85] |
| Model (Year) | Segmented Structures/Pathologies | Performance Metrics | Source (Reference) |
|---|---|---|---|
| U-Net (2015) Applied ~2017 | Retinal layers; lesions (e.g., fluid)—widely used baseline | High accuracy on healthy layers; degraded on complex pathology (lower IoUs) | Ronneberger et al., MICCAI 2015, [87] |
| ReLayNet (2017) | Seven retinal layers + intraretinal fluid (DME) | DSC ~0.77 for fluid (vs 0.58 human); ~0.9 for layers—outperforms prior methods (fluid DSC 0.28–0.67) | Roy et al., Biomed. Opt. Express 2017, [88] |
| RNN + Graph Search (RNN-GS, 2018) | Retinal layer boundaries (7 in normal; 3 in AMD eyes) | Mean boundary error ~0.53 px (normal) and 1.17 px (AMD)—competitive with CNN-based method | Kugelman et al., Biomed. Opt. Express 2018, [89] |
| DeepMind 3D U-Net (2018) | 15-class tissue map: retinal layers, fluids (IRF/SRF), PED, etc. | Enabled expert-level diagnosis (AUC ≈ 99%) using segmented maps; device-agnostic tissue representation | De Fauw et al., Nature Medicine 2018, [90] |
| DeepLabV3 (2018) | Retinal layer surfaces (e.g., ILM, RPE) in AMD patients | Low boundary errors (comparable to U-Net); slightly better RPE segmentation on Spectralis OCT | Devalla et al., Ophthalmology Science 2023, [91] |
| DME-DeepLabV3+ (2023) | Diabetic Macular Edema (fluid regions) | MIoU ≈ 91.2%, F1 ≈ 91.2%, Pixel Acc. 98.7% on DME vs. background | Guo et al., Frontiers 2023, [92] |
| Google “Whole-Volume” (2021) | Pathologies in AMD/DME: IRF, SRF, sub-RPE material, PED | Dice 0.43–0.78 (varies by lesion type; e.g., best for large fluid),—rated equal to or better than one expert in 73% of scans | Wilson et al., JAMA Ophthalmology 2021, [93] |
| GANSeg (2023) | Seven retinal layers + intraretinal fluid (cross-device adaptation) | Layer Dice up to 90% (GCL + IPL); IRF Dice ~58% (vs 79% human)—generalized to unseen device data | Lee et al., Ophthalmology 2023, [94] |
| DeepLabV3+ w/CPS (2024) | 10 retinal layers + 4 features (cysts, collapsed layers, etc. in MacTel) | Semi-supervised approach achieved highest IoUs on all 14 classes—significantly outperforms supervised U-Net, ReLayNet, etc. | Shi et al., TVST 2024, [95] |
| RetinAI Discovery (2023) (Industry) | Seven retinal layers (RNFL through RPE), choroid, subretinal & intraretinal fluid, sub-RPE material, hyper-reflective foci, etc. | N/A (Research-use only; “reliable” automated detection reported) | RetinAI (Company release) 2023, [96] |
8. Conclusions
Author Contributions
Funding
Institutional Review Board Statement
Informed Consent Statement
Data Availability Statement
Acknowledgments
Conflicts of Interest
References
- Zhou, C.; Li, S.; Ye, L.; Chen, C.; Liu, S.; Yang, H.; Zhuang, P.; Liu, Z.; Jiang, H.; Han, J.; et al. Visual impairment and blindness caused by retinal diseases: A nationwide register-based study. J. Glob. Health 2023, 13, 04126. [Google Scholar] [CrossRef]
- Nam, K.T.; Yun, C.; Seo, M.; Ahn, S.; Oh, J. Comparison of retinal thickness measurements among four different optical coherence tomography devices. Sci. Rep. 2024, 14, 3560. [Google Scholar] [CrossRef]
- Bourne, R.R.A.; Steinmetz, J.D.; Saylan, M.; Mersha, A.M.; Weldemariam, A.H.; Wondmeneh, T.G.; Sreeramareddy, C.T.; Pinheiro, M.; Yaseri, M.; Yu, C.; et al. Causes of blindness and vision impairment in 2020 and trends over 30 years, and prevalence of avoidable blindness in relation to VISION 2020: The Right to Sight: An analysis for the Global Burden of Disease Study. Lancet Glob. Health 2021, 9, e144–e160. [Google Scholar]
- Kropp, M.; Golubnitschaja, O.; Mazurakova, A.; Koklesova, L.; Sargheini, N.; Vo, T.T.K.S.; de Clerck, E.; Polivka, J.; Potuznik, P.; Polivka, J.; et al. Diabetic retinopathy as the leading cause of blindness and early predictor of cascading complications—Risks and mitigation. EPMA J. 2023, 14, 21–42. [Google Scholar] [CrossRef] [PubMed]
- Furtado, J.M.; Jonas, J.B.; Tapply, I.; Fernandes, A.G.; Cicinelli, M.V.; Arrigo, A.; Leveziel, N.; Resnikoff, S.; Taylor, H.R.; Sedighi, T.; et al. Global estimates on the number of people blind or visually impaired by age-related macular degeneration: A meta-analysis from 2000 to 2020. Eye 2024, 38, 2070–2082. [Google Scholar]
- Saeedi, P.; Petersohn, I.; Salpea, P.; Malanda, B.; Karuranga, S.; Unwin, N.; Colagiuri, S.; Guariguata, L.; Motala, A.A.; Ogurtsova, K.; et al. Global and regional diabetes prevalence estimates for 2019 and projections for 2030 and 2045: Results from the International Diabetes Federation Diabetes Atlas, 9th ed. Diabetes Res. Clin. Pract. 2019, 157, 107843. [Google Scholar] [CrossRef]
- Fleckenstein, M.; Schmitz-Valckenberg, S.; Chakravarthy, U. Age-Related Macular Degeneration: A Review. JAMA 2024, 331, 147–157. [Google Scholar] [CrossRef]
- Teo, Z.L.; Tham, Y.C.; Yu, M.; Chee, M.L.; Rim, T.H.; Cheung, N.; Bikbov M., M.; Wang, Y.X.; Tang, Y.; Lu, Y. Global Prevalence of Diabetic Retinopathy and Projection of Burden Through 2045: Systematic Review and Meta-Analysis. Ophthalmology 2021, 128, 1580–1591. [Google Scholar] [CrossRef]
- Zhang, S.; Ren, J.; Chai, R.; Yuan, S.; Hao, Y. Global burden of low vision and blindness due to age-related macular degeneration from 1990 to 2021 and projections for 2050. BMC Public Health 2024, 24, 3510. [Google Scholar] [CrossRef]
- Sikorski, B.L.; Malukiewicz, G.; Stafiej, J.; Lesiewska-Junk, H.; Raczynska, D. The diagnostic function of OCT in diabetic maculopathy. Mediat. Inflamm. 2013, 2013, 434560. [Google Scholar] [CrossRef]
- Elsharkawy, M.; Elrazzaz, M.; Ghazal, M.; Alhalabi, M.; Soliman, A.; Mahmoud, A.; El-Daydamony, E.; Atwan, A.; Thanos, A.; Sandhu, H.S.; et al. Role of optical coherence tomography imaging in predicting progression of age-related macular disease: A survey. Diagnostics 2021, 11, 2313. [Google Scholar] [CrossRef] [PubMed]
- Geevarghese, A.; Wollstein, G.; Ishikawa, H.; Schuman, J.S. Optical Coherence Tomography and Glaucoma. Annu. Rev. Vis. Sci. 2021, 7, 693–726. [Google Scholar] [CrossRef] [PubMed]
- Huang, D.; Swanson, E.A.; Lin, C.P.; Schuman, J.S.; Stinson, W.G.; Chang, W.; Hee, M.R.; Flotte, T.; Gregory, K.; Puliafito, C.A.; et al. Optical Coherence Tomography HHS Public Access. Science 1991, 254, 1178–1181. [Google Scholar] [CrossRef] [PubMed]
- Zeppieri, M.; Marsili, S.; Enaholo, E.S.; Shuaibu, A.O.; Uwagboe, N.; Salati, C.; Spadea, L.; Musa, M. Optical Coherence Tomography (OCT): A Brief Look at the Uses and Technological Evolution of Ophthalmology. Medicina 2023, 59, 2114. [Google Scholar] [CrossRef]
- Adhi, M.; Duker, J.S. Optical coherence tomography-current and future applications. Curr. Opin. Ophthalmol. 2013, 24, 213–221. [Google Scholar] [CrossRef]
- Rein, D.B.; Wittenborn, J.S.; Burke-Conte, Z.; Gulia, R.; Robalik, T.; Ehrlich, J.R.; Lundeen, E.A.; Flaxman, A.D. Prevalence of Age-Related Macular Degeneration in the US in 2019. JAMA Ophthalmol. 2022, 140, 1202–1208. [Google Scholar] [CrossRef]
- Lundeen, E.A.; Burke-Conte, Z.; Rein, D.B.; Wittenborn, J.S.; Saaddine, J.; Lee, A.Y.; Flaxman, A.D. Prevalence of Diabetic Retinopathy in the US in 2021. JAMA Ophthalmol. 2023, 141, 747–754. [Google Scholar] [CrossRef]
- Rufai, S.R. Handheld optical coherence tomography removes barriers to imaging the eyes of young children. Eye 2022, 36, 907–908. [Google Scholar] [CrossRef]
- Chopra, R.; Wagner, S.K.; Keane, P.A. Optical coherence tomography in the 2020s—Outside the eye clinic. Eye 2021, 35, 236–243. [Google Scholar] [CrossRef]
- Kumar, M.J.; Kotak, P.S.; Acharya, S.; Nelakuditi, M.; Parepalli, A. A Comprehensive Review of Ocular Manifestations in Systemic Diseases. Cureus 2024, 16, e65693. [Google Scholar] [CrossRef]
- Burns, S.A.; Elsner, A.E.; Gast, T.J. Imaging the Retinal Vasculature. Annu. Rev. Vis. Sci. 2021, 7, 129–153. [Google Scholar] [CrossRef] [PubMed]
- Panwar, N.; Huang, P.; Lee, J.; Keane, P.A.; Chuan, T.S.; Richhariya, A.; Teoh, S.; Lim, T.H.; Agrawal, R. Fundus photography in the 21st century—A review of recent technological advances and their implications for worldwide healthcare. Telemed. e-Health 2016, 22, 198–208. [Google Scholar] [CrossRef] [PubMed]
- Kornblau, I.S.; El-Annan, J.F. Adverse reactions to fluorescein angiography: A comprehensive review of the literature. Surv Ophthalmol. 2019, 64, 679–693. [Google Scholar] [CrossRef]
- Silverman, R.H. Principles of ophthalmic ultrasound. Expert Rev. Ophthalmol. 2023, 18, 379–389. [Google Scholar] [CrossRef]
- Bodenbender, J.P.; Kowalski, M.; Stingl, K.; Ziemssen, F.; Kühlewein, L. Impact of A-Scan Rate on Image Quality and Acquisition Time in OCT. Curr. Eye Res. 2023, 48, 973–979. [Google Scholar] [CrossRef]
- Aumann, S.; Donner, S.; Fischer, J. High Resolution Imaging in Microscopy and Ophthalmology; Springer: Cham, Switzerland, 2019; pp. 59–85. [Google Scholar]
- Bosche, F.; Andresen, J.; Li, D.; Holz, F.; Brinkmann, C. Spectralis OCT1 versus OCT2: Time efficiency and image quality of retinal nerve fiber layer thickness and bruch’s membrane opening analysis for glaucoma patients. J. Curr. Glaucoma Pract. 2019, 13, 16–20. [Google Scholar] [CrossRef]
- Barteselli, G.; Bartsch, D.U.; Viola, F.; Mojana, F.; Pellegrini, M.; Hartmann, K.I.; Benatti, E.; Leicht, S.; Ratiglia, R.; Staurenghi, G.; et al. Accuracy of the heidelberg spectralis in the alignment between near-infrared image and tomographic scan in a model eye: A multicenter study. Am. J. Ophthalmol. 2013, 156, 588–592. [Google Scholar] [CrossRef]
- Brennen, P.M.; Kagemann, L.; Friberg, T.R. Comparison of StratusOCT and Cirrus HD-OCT Imaging in Macular Diseases. Ophthalmic Surg. Lasers Imaging Retin. 2009, 40, 25–31. [Google Scholar] [CrossRef][Green Version]
- Munk, M.R.; Giannakaki-Zimmermann, H.; Berger, L.; Huf, W.; Ebneter, A.; Wolf, S.; Zinkernagel, M.S. OCT-angiography: A qualitative and quantitative comparison. PLoS ONE 2017, 12, e0177059. [Google Scholar] [CrossRef]
- de Carlo, T.E.; Romano, A.; Waheed, N.K.; Duker, J.S. A review of optical coherence tomography angiography (OCTA). Int. J. Retin. Vitr. 2015, 1, 5. [Google Scholar] [CrossRef]
- Chhablani, J.; Krishnan, T.; Sethi, V.; Kozak, I. Artifacts in optical coherence tomography. Saudi J. Ophthalmol. 2014, 28, 81–87. [Google Scholar] [CrossRef] [PubMed]
- Chua, J.; Tan, B.; Wong, D.; Garhöfer, G.; Liew, X.W.; Popa-Cherecheanu, A.; Loong Chin, C.W.; Milea, D.; Li-Hsian Chen, C.; Schmetterer, L. Optical coherence tomography angiography of the retina and choroid in systemic diseases. Prog. Retin. Eye Res. 2024, 103, 101292. [Google Scholar] [CrossRef] [PubMed]
- Islam, M.M.; Poly, T.N.; Walther, B.A.; Yang, H.C.; Li, Y.C. Artificial intelligence in ophthalmology: A meta-analysis of deep learning models for retinal vessels segmentation. J. Clin. Med. 2020, 9, 1018. [Google Scholar] [CrossRef]
- Karn, P.K.; Abdulla, W.H. Precision Segmentation of Subretinal Fluids in OCT Using Multiscale Attention-Based U-Net Architecture. Bioengineering 2024, 11, 1032. [Google Scholar] [CrossRef]
- Eppenberger, L.S.; Li, C.; Wong, D.; Tan, B.; Garhöfer, G.; Hilal, S.; Chong, E.; Toh, A.Q.; Venketasubramanian, N.; Chen, C.L.H.; et al. Retinal thickness predicts the risk of cognitive decline over five years. Alzheimer’s Res. Ther. 2024, 16, 273. [Google Scholar] [CrossRef]
- Murueta-Goyena, A.; Del Pino, R.; Galdós, M.; Arana, B.; Acera, M.; Carmona-Abellán, M.; Fernández-Valle, T.; Tijero, B.; Lucas-Jiménez, O.; Ojeda, N.; et al. Retinal Thickness Predicts the Risk of Cognitive Decline in Parkinson Disease. Ann. Neurol. 2021, 89, 165–176. [Google Scholar] [CrossRef]
- Choudhary, A.; Ahlawat, S.; Urooj, S.; Pathak, N.; Lay-Ekuakille, A.; Sharma, N. A Deep Learning-Based Framework for Retinal Disease Classification. Healthcare 2023, 11, 212. [Google Scholar] [CrossRef]
- Yojana, K.; Thillai Rani, L. OCT layer segmentation using U-NET semantic segmentation and RESNET34 encoder-decoder. Meas. Sens. 2023, 29, 100817. [Google Scholar] [CrossRef]
- Lim, J.I.; Regillo, C.D.; Sadda, S.V.R.; Ipp, E.; Bhaskaranand, M.; Ramachandra, C.; Solanki, K. Artificial Intelligence Detection of Diabetic Retinopathy: Subgroup Comparison of the EyeArt System with Ophthalmologists’ Dilated Examinations. Ophthalmol. Sci. 2023, 3, 100228. [Google Scholar] [CrossRef]
- Rodríguez-Miguel, A.; Arruabarrena, C.; Allendes, G.; Olivera, M.; Zarranz-Ventura, J.; Teus, M.A. Hybrid deep learning models for the screening of Diabetic Macular Edema in optical coherence tomography volumes. Sci. Rep. 2024, 14, 17633. [Google Scholar] [CrossRef]
- Borrelli, E.; Oakley, J.D.; Iaccarino, G.; Russakoff, D.B.; Battista, M.; Grosso, D.; Borghesan, F.; Barresi, C.; Sacconi, R.; Bandello, F.; et al. Deep-learning based automated quantification of critical optical coherence tomography features in neovascular age-related macular degeneration. Eye 2024, 38, 537–544. [Google Scholar] [CrossRef] [PubMed]
- Flaxel, C.J.; Adelman, R.A.; Bailey, S.T.; Fawzi, A.; Lim, J.I.; Vemulakonda, G.A.; Ying, G. Age-Related Macular Degeneration Preferred Practice Pattern®. Ophthalmology 2020, 127, P1–P65. [Google Scholar] [CrossRef] [PubMed]
- Han, J.M.; Han, J.; Ko, J.; Jung, J.; Park, J.I.; Hwang, J.S.; Yoon, J.; Jung, J.H.; Hwang, D.D.-J. Anti-VEGF treatment outcome prediction based on optical coherence tomography images in neovascular age-related macular degeneration using a deep neural network. Sci Rep. 2024, 14, 28253. Available online: https://www.nature.com/articles/s41598-024-79034-6 (accessed on 31 January 2025). [CrossRef] [PubMed]
- Singh, R.P.; Hassan, T.S.; Holekamp, N.; Khanani, A.M.; London, N.J.S. Diabetic Retinopathy: Changing Treatment Paradigms. Retina Today, 2018. Available online: https://supplements.retinatoday.com/articles/diabetic-retinopathy-changing-treatment-paradigms/diabetic-retinopathy-changing-treatment-paradigms/ (accessed on 1 February 2025).
- Berkowitz, S.T.; Finn, A.P.; Parikh, R.; Kuriyan, A.E.; Patel, S. Ophthalmology Workforce Projections in the United States, 2020 to 2035. Ophthalmology 2024, 131, 133–139. [Google Scholar] [CrossRef]
- Thompson, A.C.; Thompson, M.O.; Young, D.L.; Lin, R.C.; Sanislo, S.R.; Moshfeghi, D.M.; Singh, K. Barriers to follow-up and strategies to improve adherence to appointments for care of chronic eye diseases. Invest. Ophthalmol. Vis. Sci. 2015, 56, 4324–4331. [Google Scholar] [CrossRef]
- Burton, M.J.; Ramke, J.; Marques, A.P.; Bourne, R.R.A.; Congdon, N.; Jones, I.; Ah Tong, B.A.M.; Arunga, S.; Bachani, D.; Bascaran, C.; et al. The Lancet Global Health Commission on Global Eye Health: Vision Beyond 2020. Lancet Glob. Health 2021, 9, e489–e551. [Google Scholar] [CrossRef]
- Vujosevic, S.; Aldington, S.J.; Silva, P.; Hernández, C.; Scanlon, P.; Peto, T.; Simó, R. Screening for diabetic retinopathy: New perspectives and challenges. Lancet Diabetes Endocrinol. 2020, 8, 337–347. [Google Scholar] [CrossRef]
- Viehland, C.; Chen, X.; Tran-Viet, D.; Jackson-Atogi, M.; Ortiz, P.; Waterman, G.; Vajzovic, L.; Toth, C.A.; Izatt, J.A. Ergonomic handheld OCT angiography probe optimized for pediatric and supine imaging. Biomed. Opt. Express 2019, 10, 2623. [Google Scholar] [CrossRef]
- Duan, Z.; Huang, K.; Luo, Z.; Ma, K.; Wang, G.; Hu, X.; Zhang, J.; Luo, X.; Huang, Y.; Liu, G.; et al. Portable boom-type ultrahigh-resolution OCT with an integrated imaging probe for supine position retinal imaging. Biomed. Opt. Express 2022, 13, 3295. [Google Scholar] [CrossRef]
- Zhang, J.; Nguyen, T.; Potsaid, B.; Jayaraman, V.; Burgner, C.; Chen, S.; Li, J.; Liang, K.; Cable, A.; Traverso, G.; et al. Multi-MHz MEMS-VCSEL swept-source optical coherence tomography for endoscopic structural and angiographic imaging with miniaturized brushless motor probes. Biomed. Opt. Express 2021, 12, 2384. [Google Scholar] [CrossRef]
- Gorecki, C.; Lullin, J.; Perrin, S.; Bargiel, S.; Albero, J.; Gaiffe, O.; Rutkowski, J.; Cote, J.M.; Krauter, J.; Osten, W.; et al. Micromachined phase-shifted array-type Mirau interferometer for swept-source OCT imaging: Design, microfabrication and experimental validation. Biomed. Opt. Express 2019, 10, 1111. [Google Scholar] [CrossRef] [PubMed]
- Kim, S.; Lee, C.; Kim, J.Y.; Kim, J.; Lim, G.; Kim, C. Two-axis polydimethylsiloxane-based electromagnetic microelectromechanical system scanning mirror for optical coherence tomography. J. Biomed. Opt. 2016, 21, 106001. [Google Scholar] [CrossRef] [PubMed]
- Price, H.B.; Song, G.; Wang, W.; O’Kane, E.; Lu, K.; Jelly, E.; Miller, D.A.; Wax, A. Development of next generation low-cost OCT towards improved point-of-care retinal imaging. Biomed. Opt. Express 2025, 16, 748. Available online: https://opg.optica.org/abstract.cfm?URI=boe-16-2-748 (accessed on 24 February 2025). [CrossRef] [PubMed]
- Malone, J.D.; Hussain, I.; Bowden, A.K. SmartOCT: Smartphone-integrated optical coherence tomography. Biomed. Opt. Express 2023, 14, 3138. [Google Scholar] [CrossRef]
- Dolar-Szczasny, J.; Drab, A.; Rejdak, R. Home-monitoring/remote optical coherence tomography in teleophthalmology in patients with eye disorders—A systematic review. Front. Med. 2024, 11, 1442758. [Google Scholar] [CrossRef]
- Von Der Burchard, C.; Sudkamp, H.; Tode, J.; Ehlken, C.; Purtskhvanidze, K.; Moltmann, M.; Heimes, B.; Koch, P.; Münst, M.; Vom Endt, M.; et al. Self-Examination Low-Cost Full-Field Optical Coherence Tomography (SELFF-OCT) for neovascular age-related macular degeneration: A cross-sectional diagnostic accuracy study. BMJ Open 2022, 12, e055082. [Google Scholar] [CrossRef]
- Von Der Burchard, C.; Moltmann, M.; Tode, J.; Ehlken, C.; Sudkamp, H.; Theisen-Kunde, D.; König, I.; Hüttmann, G.; Roider, J. Self-examination low-cost full-field OCT (SELFF-OCT) for patients with various macular diseases. Graefe’s Arch. Clin. Exp. Ophthalmol. 2020, 259, 1503–1511. [Google Scholar] [CrossRef]
- Notal Vision, Inc. De Novo Classification Request for Notal Vision Home Optical Coherence Tomography (OCT) System. Manassas. 2023. Available online: https://www.accessdata.fda.gov/cdrh_docs/reviews/DEN230043.pdf (accessed on 1 April 2025).
- Giardini, M.E.; Livingstone, I.A.T. Extending the Reach and Task-Shifting Ophthalmology Diagnostics Through Remote Visualisation. In Advances in Experimental Medicine and Biology; Springer: Berlin, Germany, 2020; pp. 161–174. [Google Scholar]
- Horton, M.B.; Brady, C.J.; Cavallerano, J.; Abramoff, M.; Barker, G.; Chiang, M.F.; Crockett, C.H.; Garg, S.; Karth, P.; Liu, Y.; et al. Practice Guidelines for Ocular Telehealth-Diabetic Retinopathy, Third Edition. Telemed. e-Health 2020, 26, 495–543. [Google Scholar] [CrossRef]
- Kim, S.; Crose, M.; Eldridge, W.J.; Cox, B.; Brown, W.J.; Wax, A. Design and implementation of a low-cost, portable OCT system. Biomed. Opt. Express 2018, 9, 1232. [Google Scholar] [CrossRef]
- Song, G.; Chu, K.K.; Kim, S.; Crose, M.; Cox, B.; Jelly, E.T.; Niklas Ulrich, J.; Wax, A. First clinical application of low-cost OCT. Transl. Vis. Sci. Technol. 2019, 8, 61. [Google Scholar] [CrossRef]
- Hu, X.; Zhang, S.; Zhang, Y.; Liu, Y.; Wang, G. Large depth-of-field three-dimensional shape measurement with the focal sweep technique. Opt. Express 2020, 28, 31197. [Google Scholar] [CrossRef] [PubMed]
- Sim, I. Mobile Devices and Health. N. Engl. J. Med. 2019, 381, 956–968. [Google Scholar] [CrossRef] [PubMed]
- Gaitan, N.C. A long-distance communication architecture for medical devices based on lorawan protocol. Electronics 2021, 10, 940. [Google Scholar] [CrossRef]
- Omre, A.H. Bluetooth Low Energy: Wireless Connectivity for Medical Monitoring. Available online: www.journalofdst.org (accessed on 3 April 2025).
- Kiourtis, A.; Mavrogiorgou, A.; Kyriazis, D. Health information exchange through a Device-to-Device protocol supporting lossless encoding and decoding. J. Biomed. Inform. 2022, 134, 104199. [Google Scholar] [CrossRef]
- Bracciale, L.; Loreti, P.; Bianchi, G. Cybersecurity vulnerability analysis of medical devices purchased by national health services. Sci. Rep. 2023, 13, 19509. [Google Scholar] [CrossRef]
- Salunkhe, V.; Tangudu, A.; Mokkapati, C.; Goel, P.P.; Aggarwal, A. Advanced Encryption Techniques in Healthcare IoT: Securing Patient Data in Connected Medical Devices. Mod. Dyn. Math. Progress. 2024, 1, 224–247. Available online: https://mathematics.moderndynamics.in/index.php/mdmp/article/view/22 (accessed on 3 April 2025).
- Alkhafajee, A.R.; Ali Al-Muqarm, A.M.; Alwan, A.H.; Mohammed, Z.R. Security and Performance Analysis of MQTT Protocol with TLS in IoT Networks. In 4th International Iraqi Conference on Engineering Technology and Their Applications, IICETA 2021; Institute of Electrical and Electronics Engineers Inc.: Najaf, Iraq, 2021; pp. 206–211. [Google Scholar]
- Baumann, B.; Merkle, C.W.; Leitgeb, R.A.; Augustin, M.; Wartak, A.; Pircher, M.; Hitzenberger, C.K. Signal averaging improves signal-to-noise in OCT images: But which approach works best, and when? Biomed. Opt. Express 2019, 10, 5755. [Google Scholar] [CrossRef]
- Luo, S.; Yang, J.; Gao, Q.; Zhou, S.; Zhan, C.A. The Edge Detectors Suitable for Retinal OCT Image Segmentation. J. Healthc. Eng. 2017, 2017, 3978410. [Google Scholar] [CrossRef]
- Leandro, I.; Lorenzo, B.; Aleksandar, M.; Dario, M.; Rosa, G.; Agostino, A.; Daniele, T. OCT-based deep-learning models for the identification of retinal key signs. Sci. Rep. 2023, 13, 14628. [Google Scholar] [CrossRef]
- Karthik, K.; Mahadevappa, M. Convolution neural networks for optical coherence tomography (OCT) image classification. Biomed. Signal Process. Control. 2023, 79, 104176. [Google Scholar] [CrossRef]
- Huang, S.; Wang, R.; Wu, R.; Zhong, J.; Ge, X.; Liu, Y.; Ni, G. SNR-Net OCT: Brighten and denoise low-light optical coherence tomography images via deep learning. Opt. Express 2023, 31, 20696. [Google Scholar] [CrossRef] [PubMed]
- Li, F.; Chen, H.; Liu, Z.; Zhang, X.-D.; Jiang, M.-S.; Wu, Z.-Z.; Zhou, K.-Q. Deep learning-based automated detection of retinal diseases using optical coherence tomography images. Biomed. Opt. Express 2019, 10, 6204. [Google Scholar] [CrossRef] [PubMed]
- De Fauw, J.; Ledsam, J.R.; Romera-Paredes, B.; Nikolov, S.; Tomasev, N.; Blackwell, S.; Askham, H.; Glorot, X.; O’Donoghue, B.; Visentin, D.; et al. Clinically applicable deep learning for diagnosis and referral in retinal disease. Nat. Med. 2018, 24, 1342–1350. [Google Scholar] [CrossRef]
- Yim, J.; Chopra, R.; Spitz, T.; Winkens, J.; Obika, A.; Kelly, C.; Askham, H.; Lukic, M.; Huemer, J.; Fasler, K.; et al. Predicting conversion to wet age-related macular degeneration using deep learning. Nat. Med. 2020, 26, 892–899. [Google Scholar] [CrossRef]
- Schlegl, T.; Seeböck, P.; Waldstein, S.M.; Langs, G.; Schmidt-Erfurth, U. f-AnoGAN: Fast unsupervised anomaly detection with generative adversarial networks. Med. Image Anal. 2019, 54, 30–44. [Google Scholar] [CrossRef] [PubMed]
- Ran, A.R.; Cheung, C.Y.; Wang, X.; Chen, H.; Luo, L.Y.; Chan, P.P.; Wong, M.O.M.; Chang, R.T.; Mannil, S.S.; Young, A.L.; et al. Detection of glaucomatous optic neuropathy with spectral-domain optical coherence tomography: A retrospective training and validation deep-learning analysis. Lancet Digit. Health 2019, 1, e172–e182. [Google Scholar] [CrossRef]
- Zhou, Y.; Chia, M.A.; Wagner, S.K.; Ayhan, M.S.; Williamson, D.J.; Struyven, R.R.; Liu, T.; Xu, M.; Lozano, M.G.; Woodward-Court, P.; et al. A foundation model for generalizable disease detection from retinal images. Nature 2023, 622, 156–163. [Google Scholar] [CrossRef]
- Leingang, O.; Riedl, S.; Mai, J.; Reiter, G.S.; Faustmann, G.; Fuchs, P.; Scholl, H.P.N.; Sivaprasad, S.; Rueckert, D.; Lotery, A.; et al. Automated deep learning-based AMD detection and staging in real-world OCT datasets (PINNACLE study report 5). Sci. Rep. 2023, 13, 19545. [Google Scholar] [CrossRef]
- Carl Zeiss Meditec Inc. ZEISS CIRRUS with PathFinder. Dublin. 2024. Available online: https://asset-downloads.zeiss.com/catalogs/download/med2/aeb1432f-1d2e-44d5-99f3-78c73fa6d1d9/CIRRUS-PathFinder-Brochure-en-OUS_31_020_0021VII.pdf#:~:text=75%2C000%20OCT%20B,efficiency%20%E2%80%A2%20Automatic%20image%20assessment (accessed on 3 April 2025).
- Holm, K.B.E.; Nielsen, L.J.; Lock-Andersen, J.; Behrendt, N.; Svensson, M.S.; Themstrup, L.; Jemec, G.B.E. Optical coherence tomography for presurgical delineation of basal cell carcinomas on the face—A comparison with histopathology. J. Cutan. Pathol. 2023, 50, 441–449. [Google Scholar] [CrossRef]
- Verma, A.; Tzaridis, S.; Blazes, M.; Friedlander, M.; Lee, A.Y.; Wu, Y. Developing a 10-Layer Retinal Segmentation for MacTel Using Semi-Supervised Learning. Transl. Vis. Sci. Technol. 2024, 13, 2. [Google Scholar] [CrossRef]
- Ronneberger, O.; Fischer, P.; Brox, T. U-Net: Convolutional Networks for Biomedical Image Segmentation. Available online: http://arxiv.org/abs/1505.04597 (accessed on 18 May 2015).
- Kugelman, J.; Alonso-Caneiro, D.; Read, S.A.; Vincent, S.J.; Collins, M.J. Automatic segmentation of OCT retinal boundaries using recurrent neural networks and graph search. Biomed. Opt. Express 2018, 9, 5759. [Google Scholar] [CrossRef] [PubMed]
- Titano, J.J.; Badgeley, M.; Schefflein, J.; Pain, M.; Su, A.; Cai, M.; Swinburne, N.; Zech, J.; Kim, J.; Bederson, J.; et al. Automated deep-neural-network surveillance of cranial images for acute neurologic events. Nat. Med. 2018, 24, 1337–1341. [Google Scholar] [CrossRef] [PubMed]
- Mukherjee, S.; De Silva, T.; Duic, C.; Jayakar, G.; Keenan, T.D.L.; Thavikulwat, A.T.; Chew, E.; Cukras, C. Validation of Deep Learning–Based Automatic Retinal Layer Segmentation Algorithms for Age-Related Macular Degeneration with 2 Spectral-Domain OCT Devices. Ophthalmol. Sci. 2025, 5, 100670. [Google Scholar] [CrossRef] [PubMed]
- Bai, Y.; Li, J.; Shi, L.; Jiang, Q.; Yan, B.; Wang, Z. DME-DeepLabV3+: A lightweight model for diabetic macular edema extraction based on DeepLabV3+ architecture. Front. Med. 2023, 10, 1150295. [Google Scholar] [CrossRef]
- Wilson, M.; Chopra, R.; Wilson, M.Z.; Cooper, C.; MacWilliams, P.; Liu, Y.; Wulczyn, E.; Florea, D.; Hughes, C.O.; Karthikesalingam, A.; et al. Validation and Clinical Applicability of Whole-Volume Automated Segmentation of Optical Coherence Tomography in Retinal Disease Using Deep Learning. JAMA Ophthalmol. 2021, 139, 964–973. [Google Scholar] [CrossRef]
- Wu, Y.; Olvera-Barrios, A.; Yanagihara, R.; Kung, T.P.H.; Lu, R.; Leung, I.; Mishra, A.V.; Nussinovitch, H.; Grimaldi, G.; Blazes, M.; et al. Training Deep Learning Models to Work on Multiple Devices by Cross-Domain Learning with No Additional Annotations. Ophthalmology 2023, 130, 213–222. [Google Scholar] [CrossRef]
- Roy, A.G.; Conjeti, S.; Karri, S.P.K.; Sheet, D.; Katouzian, A.; Wachinger, C.; Navab, N. ReLayNet: Retinal layer and fluid segmentation of macular optical coherence tomography using fully convolutional networks. Biomed. Opt. Express 2017, 8, 3627. [Google Scholar] [CrossRef]
- Yordi, S.; Cakir, Y.; Kalra, G.; Cetin, H.; Hu, M.; Abraham, J.; Reese, J.; Srivastava, S.K.; Ehlers, J.P. Ellipsoid Zone Integrity and Visual Function in Dry Age-Related Macular Degeneration. J. Pers. Med. 2024, 14, 543. [Google Scholar] [CrossRef]

Disclaimer/Publisher’s Note: The statements, opinions and data contained in all publications are solely those of the individual author(s) and contributor(s) and not of MDPI and/or the editor(s). MDPI and/or the editor(s) disclaim responsibility for any injury to people or property resulting from any ideas, methods, instructions or products referred to in the content. |
© 2025 by the authors. Licensee MDPI, Basel, Switzerland. This article is an open access article distributed under the terms and conditions of the Creative Commons Attribution (CC BY) license (https://creativecommons.org/licenses/by/4.0/).
Share and Cite
Devine, B.C.; Dogan, A.B.; Sobol, W.M. Recent Optical Coherence Tomography (OCT) Innovations for Increased Accessibility and Remote Surveillance. Bioengineering 2025, 12, 441. https://doi.org/10.3390/bioengineering12050441
Devine BC, Dogan AB, Sobol WM. Recent Optical Coherence Tomography (OCT) Innovations for Increased Accessibility and Remote Surveillance. Bioengineering. 2025; 12(5):441. https://doi.org/10.3390/bioengineering12050441
Chicago/Turabian StyleDevine, Brigid C., Alan B. Dogan, and Warren M. Sobol. 2025. "Recent Optical Coherence Tomography (OCT) Innovations for Increased Accessibility and Remote Surveillance" Bioengineering 12, no. 5: 441. https://doi.org/10.3390/bioengineering12050441
APA StyleDevine, B. C., Dogan, A. B., & Sobol, W. M. (2025). Recent Optical Coherence Tomography (OCT) Innovations for Increased Accessibility and Remote Surveillance. Bioengineering, 12(5), 441. https://doi.org/10.3390/bioengineering12050441





